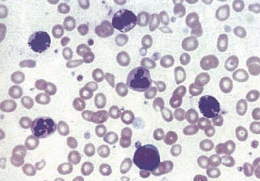
http://webres.medlive.cn/upload/000/029/961
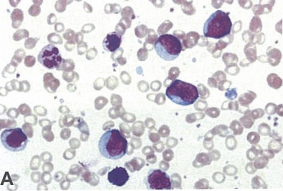
http://webres.medlive.cn/upload/000/029/968
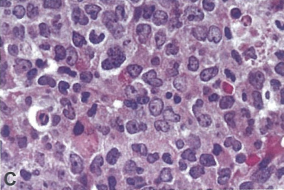
http://webres.medlive.cn/upload/000/029/970
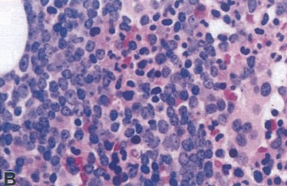
http://webres.medlive.cn/upload/000/029/972

1、慢性期(CML-CP)(图2A/B/C)
(1) 临床表现:无症状或有低热、乏力、多汗、体重减轻等症状
(2) 血象:白细胞总数升高,主要为中性晚幼和杆状核粒细胞,原粒+早幼粒≤10%,嗜酸和嗜碱粒细胞增多, 有少量有核红细胞
(3) 骨髓:增生明显至极度活跃, 粒系增生为主,中、晚幼粒和杆状核粒细胞增多,原始细胞≤10%。
(4) 染色体:费城染色体(Ph)90%以上阳性
(5) 融合基因:bcr- abl阳性率90~100%
(6) 粒一单系祖细胞(CFU-GM):集落或集簇较正常骨髓明显增加

图2A. CML-CP外周血涂片

图2B. CML-CP骨髓涂片(粒系增生明显)

图2C. CML-CP骨髓涂片(小巨核细胞)
2、加速期(CML-AP)(图3A/B)具有下列之一或以上者:
(1)外周血白细胞及(或)骨髓中有和细胞中原始细胞占10%~19%。
(2)外周血嗜碱细胞≥20%,
(3)与治疗无关的持续性血小板减少(<100×109/L)或治疗无效的持续性血小板数增高(>1000×109/L)。
(4)治疗无效的进行性白细胞数增加和脾肿大。
(5)细胞遗传学示有克隆演变
病态巨核细胞伴有网硬蛋白或胶原蛋白增加及(或)有重度病态粒系细胞应考虑为CML-AP。但此点并未经大量临床研究证明是AP的独立标准,却往往与上述特点之一成数点共存。
图3A. CML-AP外周血涂片

图3B. CML-AP骨髓涂片
3、 急变期(CML-BP)(图4,图5) 具有以下之一或以上者.
⑴外周血白细胞或骨髓有核细胞中原始细胞占≥20%,约70%病人为急髓变,可以是中性粒细胞、嗜酸性粒细胞、嗜碱粒细胞、单核细胞、红细胞或巨核细胞的 原始细胞,约20%-30%为急淋变。
⑵髓外浸润:常见部位是皮肤、淋巴结、脾、骨骼或中枢神经系统。
⑶骨髓活检示原始细胞大量聚集或成簇。如果原始细胞明显地呈局灶性聚集于骨髓,即使其余部位的骨髓活检示为慢性期,仍可诊断为BP。
图4A. CML,myeloid blast phase外周血涂片
图4C. CML,myeloid blast phase骨髓涂片

图5A. CML,lymphoid blast phase外周血涂片
图5B. CML,lymphoid blast phase骨髓涂片